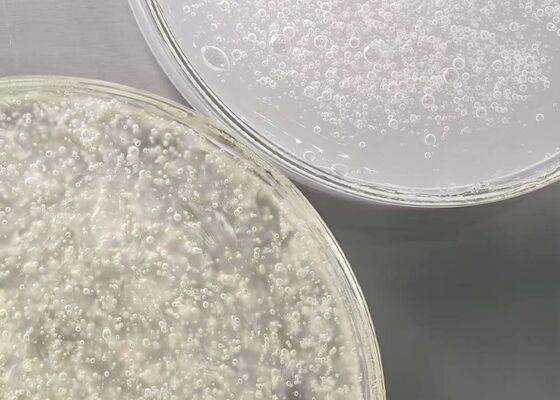
Anionic Surfactant Sodium Lauryl Ether Sulfate SLES 70% CAS 68585-34-2

Leave a Message
We will call you back soon!
Your message must be between 20-3,000 characters!
Please check your E-mail!
More information facilitates better communication.
Submitted successfully!
We will call you back soon!
Leave a Message
We will call you back soon!
Your message must be between 20-3,000 characters!
Please check your E-mail!
Shandong Jiurunfa Chemical Technology Co., Ltd. manager@chemical-sales.com 86-153-18854848
Recommend these videos for you
Chat on WhatsApp
00:30
00:40
00:36
00:34
00:30
00:07
00:37
00:16
00:18
00:39
00:06
00:09
01:01
00:15
00:10